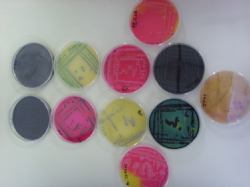

atreliu
Amministratore
  

Prov.: Milano
Città: Milano
2484 Messaggi |
Inserito il - 04 dicembre 2009 : 17:05:13
|
Sondaggio:
Dopo la pubblicazione dei lavori, eccoci alla votazione delle bellissime e numerose immagini che sono arrivate.
I circa 30 lavori sono stati suddivisi in tre sondaggi aperti agli iscritti: ciascun utente potrà votare fino a tre lavori (uno per sondaggio) fino al 12 Dicembre.
In questo modo verranno scelti quelli più belli: i 12 che riceveranno maggior voti saranno inseriti nel Calendario MolecularLab 2010
Buona votazione: buona fortuna ai partecipanti e grazie per la ricca partecipazione.
PS: Vi invito a cercare e vedere le immagini nelle dimensioni originali perchè molto più belle e ricche di particolari prima di scegliere quale votare. Inoltre ricordate che visualizzare i risultati senza votare comporta l'impossibilità di esprimere la propria preferenza. Se avete delle modifiche sui titoli delle immagini, vi prego di farmelo sapere via PM o rispondendo qui sul forum.
 Rispettivamente di: atreliu; cin; Saretta
 Rispettivamente di: Aureus; Soshi Fujiwara; Iside
Rispettivamente di: GFPina; AAlessandra; mak_steon;
Dopo la votazione di questo sondaggio, passa a votare negli altri! Sondaggio 1 Sondaggio 2 Sondaggio 3 Grazie ancora per l'alta partecipazione e la buona qualità dei lavori!
|
Risultati: |
atreliu - Subunità dell'enzima di restrizione HindIII |
[26%] |
9 voti |
cin - Cellule 293 colorate con un anticorpo AlexaFluor 488 |
[0%] |
0 voti |
Saretta - "Lab Life" |
[17%] |
6 voti |
Aureus - Sotto cappa... |
[3%] |
1 voti |
Soshi Fujiwara - Arcobaleno attraverso la vetreria che si asciuga |
[14%] |
5 voti |
Iside - Cuor di nuclei |
[20%] |
7 voti |
GFPina - Vaso sanguigno |
[9%] |
3 voti |
mak_steon - Etidio bromuro |
[0%] |
0 voti |
AAlessandra - Batteri che causano tossinfezioni alimentari piastrati su Petri |
[11%] |
4 voti |
Stato del Sondaggio:
Aperto »» |
Voti Totali: 35 contati »» |
Ultimo Voto:
22 dicembre 2009 13:20:36 |
|
|
MolecularLab.it - Animazioni, News, didattica & Community su bioinformatica, biologia molecolare ed ingegneria genetica.
BUONE REGOLE DEL FORUM: - Prima di postare qualunque cosa leggere il Regolamento! - Hai provato a cercare prima di postare il tuo problema? |
|